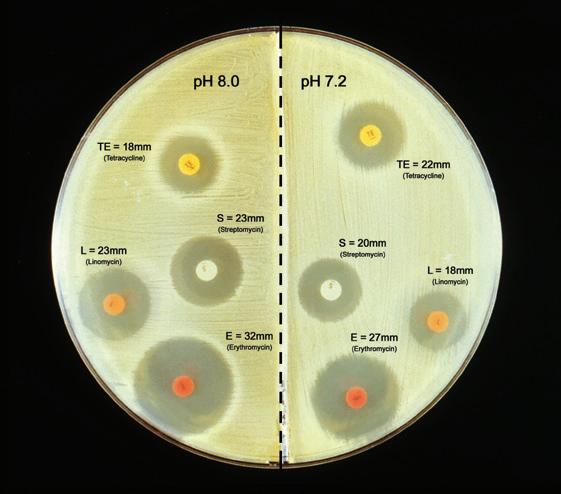
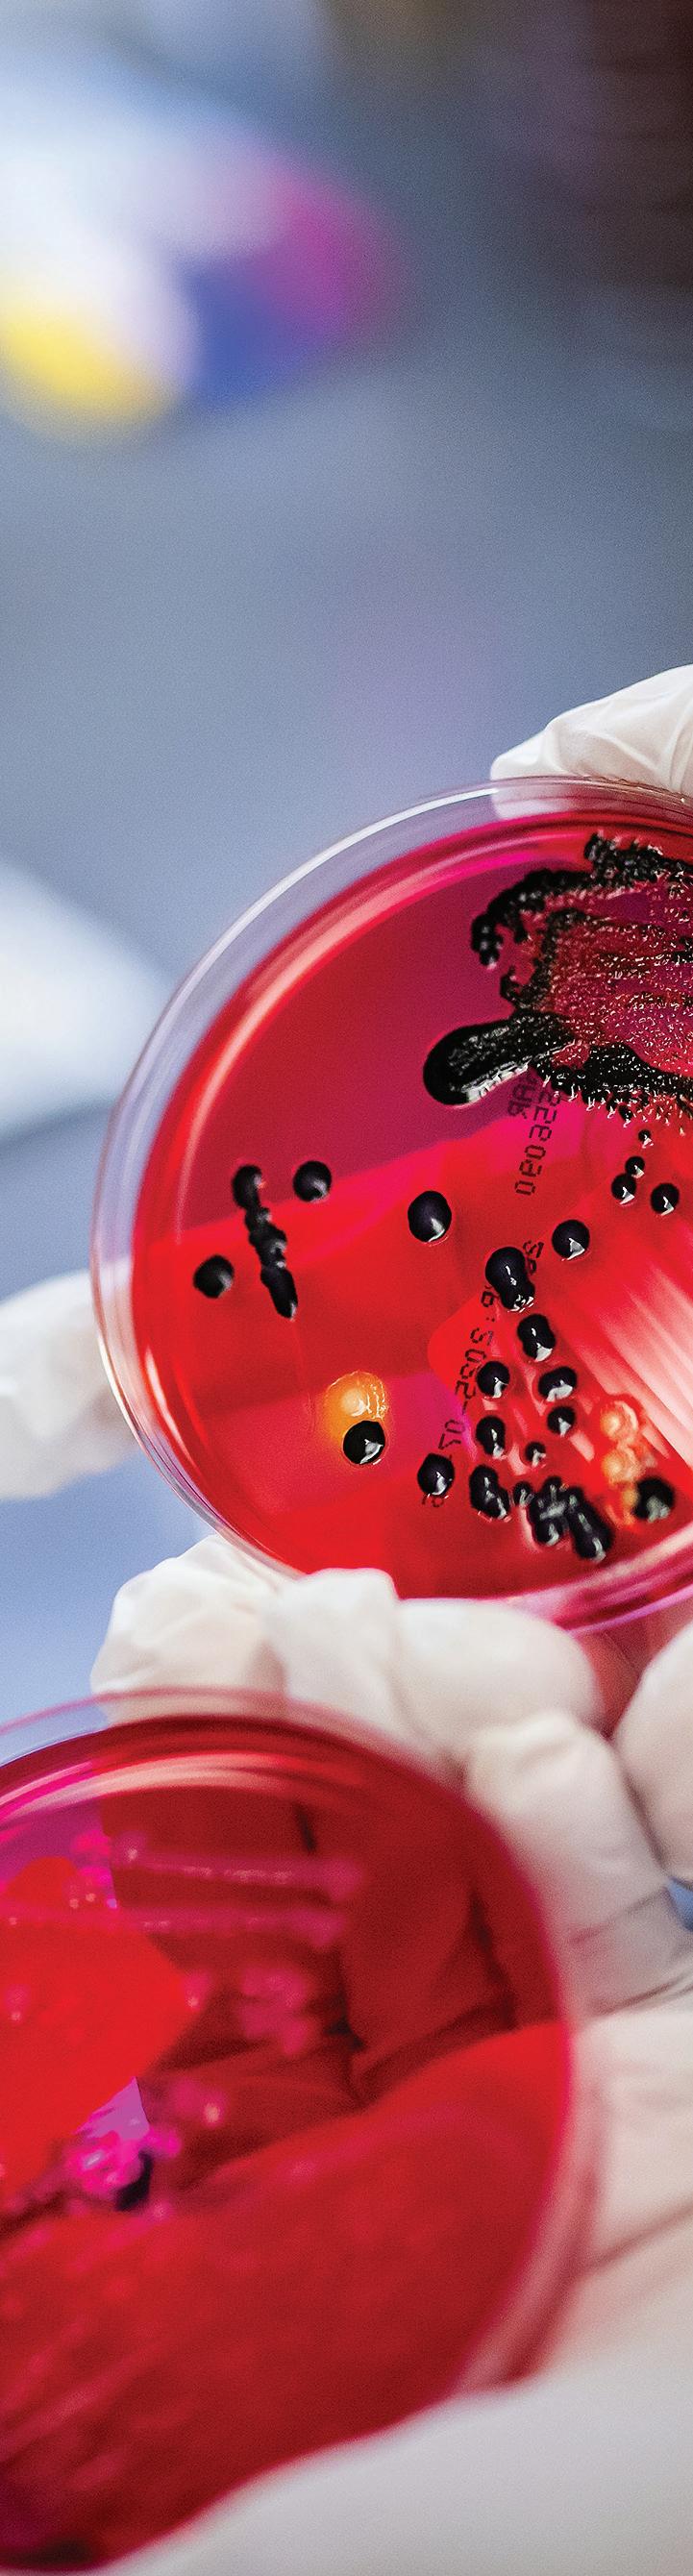

Breaking New Ground

WELCOME, CLASS OF 2029
Penn Vet’s newest cadre of veterinarians-to-be, the Class of 2029 arrived from around the world (see page 37), beginning a four-year journey to fulfill their dreams. The class gathered in front of New Bolton Center’s equine performance evaluation facility during orientation.
Breaking New Ground Gail P. Riepe Center for Advanced Veterinary Education
Jane Hinton, V’49 Unboxing a Pioneer’s Legacy
Comforting Philanthropy Ryan Hospital’s Comfort Room is Reimagined
In the Office with Donna Kelly, DVM
Explore past issues of Bellwether magazine online at pennvet.pub/bellwether-archives. ERRATA
In the Spring/Summer 2025 issue of Bellwether, Dr. Cynthia Otto’s AVMA award was incorrectly listed as the Lifetime Excellence in Research Award, instead of the Career Achievement in Canine Research Award.
Dear Friends of Penn Vet,
For us here at Penn Vet, innovation is not about change for its own sake but change in service to others. New ideas and new knowledge matter most when they help animals, people, and communities. This issue of Bellwether reflects that commitment in several ways.

Our cover story features the construction of our new learning hub, the Gail P. Riepe Center for Advanced Veterinary Education at New Bolton Center. We are building an integrated, multi-use 12,000-square-foot facility where our veterinary students can strengthen their clinical skills and gain early, hands-on experience. Made possible by the generous philanthropy of Penn alumni Gail and Jim Riepe, the Center represents an investment in innovative education, preparing students to act with compassion and certitude. The Riepe Center will be a unique, student-centric complex among our peers; a convening space that engages our educational community and inspires outreach from the School to our stakeholders in the equine and animal agriculture industries, to our alumni, our public and local communities, and the Commonwealth of Pennsylvania. The building will include two classrooms gifted by Robert “Rob” Marookian, whose father, Edgar, worked on dairy farms and in veterinary pharmaceuticals after graduating from Penn Vet in 1954. The rooms are named in memory of Robert Marookian’s mother, Myrval, and brother, Edgar.
On page 10, we explore the life of a pioneering alumna whose remarkable career was defined by bringing her knowledge to bear in the service of others. From supporting the health of Army troops during WW II, to caring for animals in her own practice, to advancing food safety and disease surveillance in the 1950s, Jane Hinton, V’49, redefined what it meant to be a veterinarian. She worked across disciplines at the intersections of medicine, microbiology, and public health. The Kislak Center at the University of Pennsylvania’s Van Pelt-Dietrich Library recently
acquired Dr. Hinton’s personal papers. Her life and her collection remind us that leadership is not only about expertise but also about vision, courage, and perseverance.
And as we look ahead, our new strategic framework, “United by Purpose. Built for Impact. 2025-2030,” carries forward our timeless values into a bold new direction. With initiatives to expand access to care, lead in One Health efforts, advance agricultural innovation, and strengthen wellness in our profession, we are charting a course that ensures our innovations serve not just Penn Vet but communities near and far. You can read more about our framework in the summary on the facing page or go to our website at www.vet.upenn. edu/strategicframework for a deeper dive into our vision, values, and goals.
Together, the stories in this issue reflect the heart of our mission: cultivating the veterinarians of tomorrow, honoring those who have paved the way, and shaping a healthier future for animals and people. Innovation and service are the threads that connect our past, present, and future. They define who we are as a community, and they will continue to guide us as we inspire the next generation to lead and serve. Whether you are a student, a graduate, or a friend, thank you for being part of Penn Vet and the mission-critical work we do.
M. HOFFMAN, DVM, DVSc, DACVIM Gilbert S. Kahn Dean of Veterinary Medicine
ANDREW
United by Purpose. Built for Impact
STRATEGIC FRAMEWORK 2025–2030
This framework, reflective of Penn’s In Principle and Practice, incorporated extensive input and collaboration from the Penn Vet community and is an acknowledgment of our strengths and opportunities for our future. Veterinary medicine is a noble profession, a calling—and together, we can be a force for good in society.
INITIATIVE ONE
Driving Better Health Care Outcomes & Access
• Modernize our two teaching hospitals to improve health care integration, operations, and access to clinical trials, including plans for a new Intensive Care Unit and Radiation Oncology Suite at Ryan Hospital, the region’s only certified trauma center for companion animals.
• Build a Primary Care, Community Health Clinic on Penn Vet’s Philadelphia campus to expand early-entry veterinary training across the spectrum of care, and bolster local community access to companion animal care and One Health interprofessional services.
• Advance new centers of excellence across core areas of strength: Equine Research, Sports Medicine & Rehabilitation, Animal Welfare & Behavior, and Germline Cell Research.
• Grow our capacity to train veterinary specialists through innovative specialty pathway programs for veterinary students.
INITIATIVE TWO
Leading Global and One Health Interdisciplinary Efforts
• Establish a University-wide One Health Institute at Penn Vet to address global challenges by recognizing the interconnectedness of animals, people, and the planet. Provide a hub for interdisciplinary and interprofessional teams to advance solutions to vexing One Health problems.
• Develop a Center on Antimicrobial Resistance (AMR) to enhance national and regional preparedness, diagnostic resources, education, and expertise on AMR.
• Create new endowed professorships to support faculty working in oncology, immunology, infectious disease, and other areas of strength.
INITIATIVE THREE
Serving Agriculture & Innovation in Animal Health
• Bolster sustainable agriculture and food security globally by intensifying scientific research on factors that contribute to climate adaptation, mitigation, resilience, economic viability, and societal valuation of farming.
• Modernize and expand research facilities for the Center for Stewardship Agriculture and Food Security and dairy operations.
• Serve as a keystone partner in the Universitywide initiatives Campus as a Living Laboratory and Nature Positive Campus.
• Reach 100% renewable electricity by 2030.
Our commitment to excellence is detailed online. Explore the full strategic framework, including our vision and values, at www.vet.upenn.edu/strategicframework
INITIATIVE FOUR Fostering Community, Engagement, and Wellness in the Profession
• Launch the Veterinary Social Work Learning Opportunity Program for house officers and VMD students, to enhance our hospitals’ level of care, and to support the well-being and communication skills of our early-career veterinarians.
• Enhance cross-cultural collaboration in veterinary medicine and increase Penn Vet clinical capacity through intentional, international, and offshore veterinary clinical exchange training.
• Increase financial aid to make veterinary education accessible to socioeconomically disadvantaged, firstgeneration, and rural students while reducing student indebtedness.
• Create communal spaces for dining, informal and formal gathering, rest and wellbeing, entrepreneurship, and flexible learning.



Create a legacy of compassion and care
Penn Vet impacts animals everywhere. Our students, faculty, clinicians, and researchers offer invaluable and compassionate care that touches lives.
Join us in our mission by considering Penn Vet in your long-term plans. By including Penn Vet in your financial and estate planning, you can leave a legacy that reflects your passion for animals while bolstering our commitment to their health and happiness, both now and in the future.
You can make a difference when you:
• Leave a gift to Penn Vet in your estate plan—you can designate a percentage or a fixed amount of your estate.
• Make Penn Vet the beneficiary of your IRA, other retirement account, or life insurance policy.
• Make Penn Vet the beneficiary of your family foundation or donor advised fund.
In making a qualified gift, you will be welcomed into Penn Vet’s Veterinary Heritage Circle and the University of Pennsylvania’s Harrison Society.
For other ways to give and for more information, please visit giving.upenn. edu/gift-planning or contact:
Shoshana Milovsky Associate Director of Major Gifts Penn Vet
vetplannedgiving@ vet.upenn.edu




From her home base in Philadelphia, Sacha Adorno writes about people, institutions, and businesses working to make the planet a better place for all life on it.
As director of content and news media, Rita Giordano tells the stories of Penn Vet’s people and animals, as well as the research and initiatives that make this a groundbreaking institution.
As associate director of social media, Ashley Hinton sniffs out stories about the people, research, and vet hospitals that make up Penn Vet. With her nose to the ground, she brings the student experience to life in print.
As a science news editor in University Communications, Deborah Stull writes for Penn Today about news from Penn Vet, Penn Med, Penn Dental, and SP2 and edits Research at Penn
EDITORIAL
EDITOR
John Donges
CONTRIBUTING EDITOR AND WRITER
Sacha Adorno
WRITERS AT LARGE
Rita Giordano, Martin J. Hackett, Ashley Hinton, Deborah Stull
CLASS NOTES EDITOR
Laura Brown
DESIGN
DESIGNER
Anne Marie Kane, Imogen Design
PHOTOGRAPHERS AT LARGE
Kerry Campbell, V’28, John Donges, Lisa Godfrey, Tyler Harold, Ashley Hinton, Emilie LaRosa, Eric Sucar
ADMINISTRATION
GILBERT S. KAHN DEAN OF VETERINARY MEDICINE
Andrew M. Hoffman, DVM, DVSc, DACVIM
SENIOR ASSOCIATE DEAN OF DEVELOPMENT AND ALUMNI RELATIONS
Jonathan Evans
CHIEF COMMUNICATIONS OFFICER
Martin J. Hackett
DIRECTOR OF ALUMNI RELATIONS
Laura Brown
CHANGE OF ADDRESS
Sarah Trout
Office of Institutional Advancement School of Veterinary Medicine
University of Pennsylvania 3800 Spruce Street Suite 151E, Philadelphia, PA 19104 strout@vet.upenn.edu 215.746.7460
None of these articles is to be reproduced in any form without the permission of the School. ©2025 by the Trustees of the University of Pennsylvania. The University of Pennsylvania seeks talented students, faculty, and staff with a wide variety of backgrounds, experiences, and perspectives. The University of Pennsylvania does not discriminate on the basis of race, color, sex, sexual orientation, religion, creed, national origin (including shared ancestry or ethnic characteristics), citizenship status, age, disability, veteran status or any other class protected under applicable federal, state, or local law in the administration of its admissions, financial aid, educational or athletic programs, or other University-administered programs or in its employment practices. Questions or complaints regarding this policy should be directed to the executive director of the Office of Equal Opportunity Programs; Franklin Building, 3451 Walnut Street, Suite 421, Philadelphia, PA 19104-6106; or 215.898.6993.





Breaking New Ground
Penn Vet Builds Future-Ready Learning Hub
BY SACHA ADORNO
On a warm spring morning last April, the Penn Vet community gathered at New Bolton Center to break ground on a milestone project: the Gail P. Riepe Center for Advanced Veterinary Education.
Set to open in the coming months, the 11,800-square-foot clinical skills center will be the first dedicated classroom space on the Kennett Square campus, ushering in a new era of teaching and learning with high-fidelity veterinary simulators, flexible multimodal classrooms, and spaces for school and public events.
“This facility will align our teaching spaces with the level of science and clinical care happening here every day,” said Amy Durham, MS, VMD, MSEd, DACVP, associate dean of education, who offers the dual perspective of faculty and alumna of the School’s Class of 2005.
“I remember sitting in a classroom with 1970s-era chairs and flip-up desks. The teaching was worldclass, but the learning space didn’t necessarily match. Now they will.”
When construction is finished in spring 2026, the Riepe Center will offer state-of-the-art spaces and technology to prepare today’s veterinarians for every aspect of practice. The facility, said Durham, will “foster a comprehensive learning experience that bridges the theoretical knowledge we impart in lectures with practical application, ultimately preparing our students for clinics and beyond.”
Training 21st-century veterinarians
The building will feature two high-fidelity simulation labs where students practice procedures on large- and small-animal models in controlled settings. Dedicated breakout rooms will host communication labs, moving role-playing exercises with simulated clients into purposebuilt spaces. Anchoring the facility will be a multipurpose lecture hall that serves as both a venue for large presentations and a flexible classroom for small-group sessions and “flipped” instruction, which shifts lectures outside the classroom and uses class time for active learning. And, importantly, a fabrication lab will enable faculty and students to design and produce training models, ranging from simple tools to advanced replicas for complex procedures.
The design reflects Penn Vet’s curriculum, launched in 2022, which emphasizes early hands-on training. Preclinical courses are condensed into the first two years, freeing the final two years for clinical rotations and electives. To support first- and
“With the new center, we’ll finally have the space to bring more of the wider community to our campus.”
Barbara Dallap Schaer, VMD, DACVS, DACVECC, hospital director and associate dean for clinical education and operations
second-year students who are not yet ready for patient care, the center will provide a safe environment for developing competencies. Through realistic simulations— using lifelike models, scenarios, and environments that mirror real-world practice—students can refine skills, make mistakes, and learn without risk to themselves or patients.
“At its core, the Riepe Center is going to change the way we teach,” said Barbara Dallap Schaer, VMD, DACVS, DACVECC, hospital director and associate dean for clinical education and operations at New Bolton Center and a Penn Vet alumna. “Students are mastering
so much at once—thinking like doctors, handling unfamiliar patients, building psychomotor and technical skills, and learning to communicate with clients. Our goal is to break this complex, multifaceted process of becoming a clinician into smaller, more approachable steps that are easier to master.”
Dallap Schaer also sees opportunities for collaboration with other Penn schools. One current project with the School of Engineering, as an example, is exploring haptics and mixed-reality training. “Instead of having a student simply read about repairing a condylar fracture, you can hand them a model. With smart glasses, they’ll see exactly how to align the drill and, through haptic feedback, actually feel what that procedure is like,” she said.
Bringing the outside in
But the center is not only for Penn Vet people. Its reach will extend beyond the campus, reinforcing the School’s role as a resource for the wider community.

Breaking ground (left to right): Scarlett Loya, Amy Durham, J. Larry Jameson, Jim Riepe, Gail P. Riepe, Andrew M. Hoffman, Robert Marookian, and Barbara Dallap Schaer. (Photo by Lisa Godfrey)

“With the new center, we’ll finally have the space to bring more of the wider community to our campus,” said Dallap Schaer. “Our First Tuesday Lectures already draw strong interest, but the current room holds only 70 or 80 people and fills quickly. The Riepe Center will let us expand those programs and create new opportunities to engage local farmers, the agricultural community, and young people interested in large-animal medicine and agriculture. It gives us the forum we’ve needed to integrate New Bolton Center with our surrounding community more closely.”
A project built on partnership
The vision for the Riepe Center was born out of a close partnership with its namesake, Gail P. Riepe, CW’68, a longtime Penn Vet supporter. In July 2020, the School announced a $6 million leadership gift for the facility from Gail and her husband Jim, W’65, WG’67, HON’10. The couple has been active at Penn for many years. Gail is a member of Penn Vet’s Board of Advisors, and Jim is a past chair of both the University’s Board of Trustees and the Penn Medicine Board.
“Gail and Jim are incredibly insightful and deeply committed
philanthropists,” said Dallap Schaer. “They are always focused on students, teaching, and training. What stood out for me in the development process was how genuinely Gail wanted to hear from the people who will use the center.”
Riepe spent time listening to students and house officers, whose input shaped the building’s design. “She wanted to know what would make their training stronger,” said Dallap Schaer, adding that the new center reflects their answers.
“We want to support students and provide the very best experience for them. The work of preparing tomorrow’s veterinarians is so incredibly important,” said Gail. “Investment in students pays wonderful dividends when Penn
graduates bring their knowledge and skills to veterinary practices near and far.”
A promise for the future
The visionary investment of social and financial capital has already had a multiplier effect. “While I will not be taught in the building, I can share from experience how much of a difference the investments in education make for students like me and students of Penn Vet,” said Scarlett Loya, V’25. “Knowing that there are people who are deeply invested in our futures and the future of veterinary medicine is motivating for us to do our best while we’re here and strive for excellence in our careers ahead.”
In the meantime, with construction well underway, anticipation is building for move-in day. “We’ll start by gathering all the teaching models and equipment that have been tucked away in corners of the hospital and bring them under one roof,” said Dallap Schaer. “From there, we’ll layer in new labs, 3D printers, and communication spaces, and evolve the space over time. It’s a phased approach, but each step makes the center come alive a little more.”

Gail P. Riepe, in pink, hosted a roundtable discussion with New Bolton Center faculty, students, and house officers to gather input on the design and expectations of the future Center.
Construction of the Riepe Center is well underway in the northwest corner of New Bolton Center’s campus. (Photo by Tyler Harold)
ALUMNI PROFILE
Unboxing a Pioneer’s Legacy
Jane Hinton’s Collection Comes to Penn
BY SACHA ADORNO
Born in 1919, Jane Hinton, V’49, came of age when opportunities for women in science and medicine were scarce — and for Black women, nearly nonexistent.
Nevertheless, by the time she was 30, Hinton had already made an indelible mark in microbiology when she achieved a second, historymaking milestone: graduating from Penn Vet as one of the first two Black women veterinarians in the U.S. (Alfreda Johnson Webb, a Tuskegee University graduate, was the other.)
Between college and veterinary school, Hinton served as a laboratory technician for the U.S. War Department at Fort Huachuca, Arizona. And after earning her VMD, she returned to her hometown of Canton, Massachusetts, where she practiced as a small animal veterinarian. She later joined the U.S. Department of Agriculture in Framingham as a federal inspector, contributing to research and outbreak response related to livestock diseases.
Yet, for all her accomplishments, Hinton is little known outside scientific and veterinary circles. Now, a special gift to Penn Vet and the Kislak Center for Special Collections, Rare Books, and Manuscripts at the University of Pennsylvania Libraries will help change that.
Recently, Penn acquired the Jane Hinton Collection, an archive of the trailblazerʼs personal papers, photographs, and memorabilia. From her childhood scrapbooks to wartime photo albums, veterinary school mementos to public health papers, the collection paints an intimate portrait of a woman whose influence spanned science, medicine, and history. It also provides a glimpse into Hinton’s interests beyond her professional life.
A scholarship award has been named in Hinton’s honor. If you would like to donate, please email vet-advancement@vet.upenn.edu.

Jane Hinton
Recently, Penn acquired the Jane Hinton Collection, an archive of the trailblazer’s personal papers, photographs, and memorabilia.
Bellwether spoke with Rae Thudium (left), head of head of Penn Veterinary Libraries, and Mitch Fraas (right), senior curator of Special Collections at the Kislak Center, who helped bring the collection to Penn Vet, about its discovery and acquisition, and why Hinton’s legacy continues to resonate today.
How did Penn acquire the collection?
THUDIUM: It was a bit of serendipity—and a little bit of a scramble. Early this year, we learned that a cache of Hinton’s papers was coming up for auction in New York as part of a sale of African American historical manuscripts. You can imagine our surprise: Dr. Hinton is an alumna of Penn Vet, yet we had no idea her diaries, photos, and certificates existed. Once we confirmed the lot was truly her collection, our team moved quickly to bid.
FRAAS: The auction opened higher than expected, and bidding was steep and competitive. I remember thinking, “It’s gone.” Fortunately, one of our donors and alumni—Caroline Schimmel, CW’67—was at the auction and stepped in. In an almost storybook ending, she bid on the items on our behalf. Thanks to her gift, we were able to secure the collection for the Penn Libraries. When the gavel fell, we cheered. And we’ve since acquired eight more boxes of Hinton’s papers and collections.

What do the materials reveal about her life?
THUDIUM: We knew the big points. The collection fills in details, showing a whole person with humor and quirks. Many of the pieces are personal. Her teenage scrapbook includes boxing clippings and odd newspaper headlines from her hometown. A family Bible from the 1840s sits alongside USDA disease reports and her Penn Vet diploma. Then there are candid photos from her Army years—soldiers at Fort Huachuca, Buffalo Soldiers regiment patches, camp newsletters. These are all textures of daily life.
FRAAS: The collection shows a determined, curious person who loved animals and science. Her Penn Vet classmates elected her class secretary and historian, indicating that she was well-respected among her peers. We see that she’s significant not only as a “first,” but also as a leader, colleague, and professional who excelled across disciplines.
Hinton’s resilience also comes through. Her parents sent her
abroad to avoid segregated schools in the U.S., but she returned to pursue higher education here at home. Later, she went into rural communities as a government inspector. Working as a Black woman veterinarian in the 1950s, showing up on farms—I think it’s safe to say that it took a great deal of grit. The papers in the collection serve as a testament to her courage and determination.
THUDIUM: Additionally, Hinton was a trailblazer on many fronts. She co-developed a medium that remains the global standard for antibiotic susceptibility testing, and she was one of the first Black women in the country to earn a VMD. That alone is remarkable. What also stands out is the way her life bridged three fields: microbiology, veterinary medicine, and public health. That range feels very modern —very “One Health”—but she was doing it more than 70 years ago.
The materials span Hinton’s childhood, wartime service, scientific work, and more. How do you see this collection having an impact?
THUDIUM: Representation matters. Veterinary medicine has not always recorded or acknowledged the contributions of women, and even less so those of Black women. Now students, faculty, and historians can literally hold pieces of her life—her diploma, class yearbook, or lab notes—and learn from a pioneering alumna. The collection reinforces that different voices and talents in STEM isn’t a new idea.
FRAAS: The impact will extend far beyond Penn. For example, her lab reports from the 1940s are highly valuable to scholars of science and medicine. Public health historians may learn from her papers on food safety and disease surveillance. Military historians may be interested in her experiences during World War II. Her papers intersect veterinary medicine, microbiology, civil rights, women’s history, and Black history. It’s precisely the kind of collection that sparks interdisciplinary research and new scholarship.
Personally,
what struck you most when going through the collection?
FRAAS: For me, it was the DEA license. It’s an ordinary document, but it signaled her authority as a scientist and practicing veterinarian at a time when the field was far from integrated.
THUDIUM: I was taken with the photographs. Some look like professional magazine shots— beautifully composed images of soldiers and camp life. They remind you that archives aren’t just data; they’re glimpses into how someone saw themselves and their times.
The Hinton Collection is now being carefully cataloged and organized. Thudium and Fraas expect the collection will be ready for exploration by the start of the next academic semester.
Below is a map detail from the 1934 “Plan of the Town of Canton, Massachusetts,” showing the water supply system and location of hydrants, fire alarm boxes, and fire department districts.
What
are your hopes for how people will use the
Hinton Collection?
THUDIUM: We hope it will be studied and shared widely. I’d like to see students use the papers for projects and theses. Imagine a veterinary student writing about her influence on antibiotic testing, or a history student exploring the experience of Black women during World War II. The items— congratulatory letters from family friends, handwritten notes from colleagues—make her history come alive.
FRAAS: I hope it encourages more collecting. Jane Hinton’s story could have been lost. Without the auction, these papers might never have surfaced. How many other scientists—especially women and people of color—have archives tucked away in attics? Maybe seeing Hinton’s collection will inspire families to donate or institutions to seek out these histories. On a personal level, I hope anyone who encounters her collection feels what we felt opening it: a connection to a remarkable woman. Her legacy, in her own handwriting and photographs, can educate and inspire future generations. ●



Childhood and family // 1919
Jane Hinton was born in Canton, Massachusetts. Her mother, Ada Hawes Hinton, was a schoolteacher. Her father, William Augustus Hinton, MD, was a bacteriologist and pathologist who developed a widely used diagnostic test for syphilis. He was the first Black professor at Harvard Medical School and the first Black author of a medical textbook.
The Hintons sent Jane, at the age of six, and her sister to school in Europe. Jane eventually returned to the U.S. for high school and graduated from Montpelier Seminary in 1935.
Clockwise, a Hinton family photo: Parents William and Ada with Jane and her sister. A young Hinton pictured in her baby book. Hinton’s childhood scrapbook. Newspaper articles in her scrapbook.
Education and early career // 1939
Hinton earned a bachelor’s degree from Simmons College in 1939. She then trained at Harvard University in the Department of Bacteriology and Immunology, working with John Howard Mueller, a biochemist, pathologist, and bacteriologist. With Mueller, she co-developed the Mueller–Hinton agar. The culture medium enables scientists to grow bacteria in a way that doesn’t interfere with antibiotic tests.

Clockwise from right: Petri dish showing an antibiotic test on Mueller-Hinton agar. Memorabilia from Hinton’s college days at Simmons and her diploma. Hinton’s Simmons College thesis was titled “A Public Health Survey of Canton, Massachusetts.” The 183-page manuscript was completed in May 1939.









World War II service // 1945
Hinton served as a medical laboratory technician for the U.S. War Department at Fort Huachuca, Arizona, during World War II. She worked in the Army hospital laboratories supporting the health of Black troops stationed at the base. Building on her bacteriology training, she performed diagnostic and clinical lab work essential for infection control and troop readiness.
Above from left, Hinton’s civilian employee button. Photos from Hinton’s wartime scrapbook capture life on the base. The cover of her Fort Huachuca scrapbook. Hinton’s collection of “Buffalo Soldier” patches, connected to the regiments stationed at Fort Huachuca.
Veterinary career // 1949
After the war, Hinton entered Penn Vet. She was elected class historian and class secretary and graduated with her VMD in 1949. Following graduation, she returned to Canton and established a small-animal practice, serving the local community.
Counterclockwise from left, Hinton’s copy of her 1949 Scalpel yearbook. Her University of Pennsylvania diploma. Notification of Hinton’s receiving her Massachusetts veterinary license. Hinton and Webb were the first Black members of the Women’s Veterinary Medical Association.



Veterinary career // 1955
In 1955, Hinton transitioned from private practice to a public service role, serving as a federal government veterinary inspector based in Framingham, Massachusetts. In the role, she investigated livestock disease outbreaks, tracked public health risks, and authored reports on issues ranging from dairy safety to wastewater management. The responsibilities positioned her as an early practitioner of what we now call “One Health,” which recognizes the connections between environmental conditions, animal health, and human well-being.
Clockwise, Hinton’s controlled substances registration certificate issued by the Massachusetts Department of Public Health, and materials for the United States Drug Enforcement Administration. Slide from Hinton’s U.S. Department of Agriculture days.
Retirement // 1960
After retiring in 1960 at age 41, Hinton lived quietly in Canton, Massachusetts, tending her garden and caring for her animals at home. She remained there until her death in 2003, just shy of her 84th birthday.
Hinton’s collection includes letters written to and from friends and family post-retirement. Bottom-right corner, pink and blue examination books from lifelong-learner Hinton’s Northwestern University Statistics course taken in 1968.




Comforting Philanthropy
BY SACHA ADORNO
At Penn Vet’s Ryan Hospital, world-class clinical care is matched with deep compassion for animals and the people who love them. This commitment takes many forms — sometimes it’s lifesaving treatment, and sometimes it’s the way the hospital helps families say goodbye.

p The reimagined Comfort Room offers a private, home-like setting.
To honor that promise, the hospital unveiled its newly renovated Comfort Room this summer. Formerly known as the Rainbow Room, the space offers clients a private, home-like setting to spend precious time with their pet at the end of life.
“It doesn’t feel like an exam room, and that’s the point,” said Alea Cummings, MSW, LCSW, associate director of wellbeing and veterinary social worker. “We want a space for families and animals that is more comfortable than clinical.”
Comfort rooted in philanthropy
Miriam Mandell, a longtime supporter of Penn Vet and a lifelong animal lover, inspired the creation of the Comfort Room.
In 1997, Miriam and her husband, Seymour Mandell, brought their 13-year-old Bouvier des Flandres, Ursala, to Ryan Hospital for care. At
the time, the hospital didn’t have a private space for families, like the Mandells, who were facing the loss of a pet. The experience left a deep impression. A year later, the Mandells made a gift to create the original Rainbow Room.
More than 20 years after the Rainbow Room opened, Penn Vet’s care team saw the opportunity to reimagine it. Mandell made another philanthropic investment and helped guide the design of what is now the Comfort Room.
Designed with intent
The new Comfort Room feels both warm and safe. Plush couches and chairs are made of medical-grade materials to meet infection-control standards. Laminate flooring resembles hardwood without compromising safety. Dimmable lighting creates a calming ambiance that families can adjust to their preference. Wireless speakers allow for meaningful music or soothing natural sounds. And carefully chosen artwork and multiple seating options make the room welcoming and accessible.
Privacy was also a priority. The room is situated near a rear exit, allowing clients the option of leaving without having to navigate the hospital lobby.
“In moments of grief, small choices matter,” said Cummings. “Which way you exit, whether there’s music playing, even the tone of the lighting—the details restore a sense of control at a time when so much feels out of a family’s hands.”
“The
Comfort Room is one of the most meaningful spaces in the hospital. It ensures families experience empathy and comfort when they need it most. It is a sanctuary that honors the animals who pass through our doors, the families who love them, and the donor whose vision made it possible.”
Alea Cummings, MSW, LCSW Associate Director of Wellbeing & Veterinary Social Worker
A place for care and conversation
Although the Comfort Room is most often used for euthanasia, it is also a setting for difficult conversations around diagnoses, care options, and end-of-life decisions.
Members of Penn Vet’s social work team, supported by trainees from area social work programs, meet families in the room to provide grief counseling and support.
In addition to grief work, the team often helps families facing complex challenges such as domestic violence, housing insecurity, or behavioral issues with pets. In these cases, the Comfort Room is a space for advocacy and assistance.
Carrying forward a legacy
Mandell’s support of the Comfort Room gift was personal. She gave generously so others could have what she’d wished for in her own moments of loss.
“The Comfort Room is one of the most meaningful spaces in the hospital,” said Cummings. “It ensures families experience empathy and comfort when they need it most. It is a sanctuary that honors the animals who pass through our doors, the families who love them, and the donor whose vision made it possible.”
p Recognition signage as it will appear in the Comfort Room.

IN THE OFFICE WITH Donna Kelly, DVM, MASCP, DACPV, DACVPM
Assistant Professor of Clinical Microbiology
By Sacha Adorno
Donna Kelly, DVM, MASCP, DACPV, DACVPM, shares her New Bolton Center office with the campus’s microbiology reference library. But beyond the stacks of books and journals, what catches the eye is a menagerie of quirky objects that reflect Kelly’s maximalist taste and expertise in poultry and fish health.
“Basically, my office is a mess,” Kelly laughed. “But it’s a fun mess.”
Kelly began in poultry medicine as a resident at Penn Vet. From there, she advanced through leadership roles at the Georgia Poultry Laboratory Network and Clemson University before returning to the School’s New Bolton Center campus several years ago.
Although her early work focused on birds, Kelly has since expanded her portfolio to fish pathology. “We like to joke in the industry that fish are the ‘chicken of the sea,’” she added. “Really, fish or poultry, it’s all population medicine—looking at how the environment and animal and human populations exist together.”
At Penn Vet, Kelly oversees the microbiology lab. Her work centers on disease surveillance and food safety,
everything from advising on avian influenza to developing diagnostic protocols for aquaculture and conducting research on antimicrobial resistance that informs One Health strategies across veterinary and human medicine.
Board-certified in clinical microbiology and poultry medicine and a diplomate of the American College of Veterinary Preventive Medicine, Kelly is also part of the Pennsylvania Animal Diagnostic Laboratory System (PADLS), a partnership among Penn Vet, the Pennsylvania Department of Agriculture, and Penn State. By delivering timely and accurate diagnoses, PADLS supports the agricultural community in controlling disease and reducing economic loss. (See more about PADLS on page 20.)
Outside the office, Kelly is involved with the Girl Scouts of the USA, Scouting America (formerly the Boy Scouts), and her church.
“I love what I do, and I like to have fun while I’m doing it,” she said. “The things in my office? They make me smile. Some days, that’s just what you need.”
Fish From fieldwork to fungus

1. Usually, when fish have a secondary fungal infection, they develop cottony tufts that look a bit like this glaze.
2. The puzzle was a parting gift from my Clemson colleagues. I call it my unofficial fish pathology degree.
3. No backstory for the wooden rainbow trout and bass. I just like them.
4. My sister thought these fish were hideous; I think they’re extremely silly and bought them to annoy her — in a loving way, of course! The planter holds stress balls, which are great to have around.
5. Reframing your mindset is the best way to navigate almost anything. I use this lesson often, whether at work or with the Scouts, because mindset is everything.
Birds
Chickens, quail, and comic relief I started collecting bird things when I was a resident. Many of the objects I now have were gifts, but when I travel to conferences, my avian pathology friends and I take some free time to scour thrift stores for bird-themed treasures.
At Clemson, the mammalian pathologists handed me fish and said, ‘They’re yours.’ I explained my experience was in poultry. They said, ‘You’re halfway there — fish, like birds, have nucleated red blood cells.’ Since then, I’ve worked primarily with commercial finfish, but I’m starting to move from freshwater to marine fish — it’s all fascinating. 6.






6. When my son was in Boy Scouts, I completed the Wood Badge, an adult leadership training program. Bobwhite quails were my patrol. These little knickknack bobwhites and mug are a nod to that.
7. This pencil cup was an Easter planter filled with pens I’ve collected from decades of poultry conferences— the ’90s were a heyday for chicken freebies.
8. I’m a catechist and attend conferences for people who teach religious education. At one, I purchased this small wooden St. Brigid, patron saint of chicken farmers. It’s leaning against a ceramic egg cup my son made — he was so proud when to give it to me.
9. I had a calendar featuring these chicks doing yoga and then found these prints. They’re hysterical!





Keeping Food Safe and Animals Healthy

A strain of the H5N1 virus —best known for causing avian influenza—was detected in U.S. dairy cattle for the first time in March 2024. It has since spread to more than 1,000 herds across 17 states.
With dairy one of the top sectors in an agricultural industry worth hundreds of billions of dollars annually, the outbreak raised concerns not only about risks to animal and human health, but also about its economic impact.
But none of those herds are in Pennsylvania, thanks in large part to the work done by the Pennsylvania Animal Diagnostic Laboratory System (PADLS), established in 1991 by the Pennsylvania Animal Health and Diagnostic Commission.
The PADLS lab system was—coincidentally—born out of a 1983 avian influenza outbreak in Pennsylvania that had a significant impact, said Michael Smith, Ph.D., the University’s senior director of Commonwealth relations. “In the
BY DEBORAH STULL Penn Today
“WE’RE HERE TO ACCURATELY DIAGNOSE DISEASE IN ANIMALS. WE’RE HERE TO PROTECT FOOD SAFETY. AND WE ALSO ENSURE PUBLIC HEALTH THROUGH WHAT WE DO.”
Lisa Murphy Professor, Penn Vet Resident Director,
PADLS New Bolton Center
immediate years that followed, state officials and animal health experts— including those at Penn Vet— realized that there had to be a better way.”
“PADLS is here in Pennsylvania for lots of reasons,” said Lisa Murphy, VMD, DABT, professor of toxicology at Penn Vet and resident director of PADLS at New Bolton Center. “We’re here to accurately diagnose disease in animals. We’re here to protect food safety. And we also ensure public health through what we do.”
“Each lab has a base set of capabilities that are shared across the entire system,” said Smith. “That is one of the virtues of this system— redundancy,” he added. “If anything were ever to happen to one of the three existing labs, the other two are in a position to step in to meet the industry’s needs.” But he added, they do differ in the types of specialized services that they offer.
“The lab at New Bolton Center, for example, is the only one of the three that has toxicology capabilities.”
“PADLS is an indispensable tool as Pennsylvania’s first line of defense against devastating animal diseases like highly pathogenic avian influenza (HPAI),” said Alex Hamberg, V’03, Pennsylvania’s state veterinarian and director of the Bureau of Animal Health and Diagnostic Services. “The work of the labs also protects public health in instances of foodborne illness and rabies that affect humans but are spread by animals.”

Partnering with farms to monitor milk and eggs
In Pennsylvania, agriculture is big business, with an economic impact “well north of $130 billion,” according to Smith. “By many accounts, it is the largest industry in Pennsylvania when you include the hardwoods industry and food processing and manufacturing,” said Smith. “When you get into Lancaster County, that is some of the most populated and important agricultural land in all of America.”
“Dairy is the largest animal sector,” he continued, “but poultry, beef, and swine production are also significant.”
In response to the detection of H5N1 in U.S. dairy cattle, the Pennsylvania Department of Agriculture required bulk milk testing to mitigate the risk
p
egg
Extracting
yolk from quail eggs to screen for the presence of Influenza A.
(Photo: Eric Sucar/Penn Today)

of Influenza A—including HPAI—in November 2024, ahead of the mandate from the U.S. Department of Agriculture (USDA) in December 2024.
“[The outbreak] has actually added a whole new component in terms of the animal health and the food safety testing that we’ve been doing,” explained Murphy. Most of the milk testing is done at the Penn State PADLS site—a total of 22,705 samples as of June 13, 2025—she added, but PADLS-NBC has tested 890 samples since it started testing in May 2024.
“[Pennsylvania is] currently at Stage Four [HPAI-free status], which is the highest stage a state can achieve,” said Murphy. “We were the first major dairy-producing state to reach that stage.” She added that to date, no dairy cows have tested positive for H5N1 in Pennsylvania.
In addition to monitoring milk, PADLS-NBC also supports the
poultry industry, including with its Pennsylvania Egg Quality Assurance Program, or PEQAP, which Murphy said is a monitoring program to ensure that Pennsylvania eggs are free of Salmonella.
PEQAP includes basic preventative measures such as cleaning and disinfecting between flocks, intensive rodent control, environmental monitoring of pullet (young hens) and layer (egg-laying hens) houses, and only introducing chicks that have been certified free of Salmonella.
Before PEQAP was implemented in 1994, eggs were tested for Salmonella, explained Murphy, but that process was neither standardized nor widespread. In 1992, when PADLS tested eggs from just 134 flocks from 76 farms, Murphy said 23% of eggs and 38% of the manure samples tested positive. But by 2001, those numbers were 1.5% and 11%, respectively. And in
2010, when eggs from approximately 300 flocks from more than 180 farms were tested as part of the program, only 0.011% of eggs and 1.85% of manure samples tested positive.
The program is voluntary, Murphy explained, but it is “the basis for the national model that’s now in place everywhere by the Food and Drug Administration to similarly make sure that eggs in the store are safe.”
Tracking and containing diseases and environmental contaminants
But PADLS-NBC offers more than these two services, said Murphy. In fact, as the only site in the PADLS system with a toxicology lab, it is uniquely positioned to help monitor a broader spectrum of risks and threats—both natural and humanmade—to animals and potentially people.
For example, said Murphy, PADLS-NBC is developing tests to detect new and emerging toxicants such as insecticides like neonicotinoids and “forever chemicals” like per- and polyfluoroalkyl substances (PFAS)— including perfluorooctane sulfonic acid (PFOS)—which are used as a coating for paper and cardboard food packaging, carpets, fabrics, nonstick cookware, and more.
“[PFAS and PFOS] have gotten a lot of concern in terms of environmental contamination,” said Murphy. She explained that PADLS-NBC has been assisting the Pennsylvania Game Commission in evaluating the risks they may pose to wildlife and to humans who consume venison or
p Nicole Morrison and Rob Briley preparing to test manure samples for Salmonella.
(Photo: Eric Sucar/Penn Today)
“IT IS HELPING TO PROTECT THE SAFETY OF PEOPLE, IT IS HELPING TO PROTECT THE SAFETY AND HEALTH OF ANIMALS, IT IS HELPING TO PRESERVE THE VIBRANCY AND VITALITY OF A VERY IMPORTANT ECONOMIC INDUSTRY FOR THE STATE.”
Michael Smith, Senior Director of Commonwealth Relations, University of Pennsylvania
fish. PADLS-NBC is also working with the PA Department of Agriculture to determine whether these chemicals pose a risk to milk.
If state or federal agencies—like the USDA, for example—need to conduct an investigation and require assistance identifying an infectious or contagious animal disease, said Murphy, or if there are concerns about animal or human food safety, “we’re able to provide local support.”
PADLS-NBC also works directly with veterinarians and farmers to help them assess the health and wellbeing of their animals by identifying nutritional and/or metabolic issues. Providing this service “actually gives us the ability to help—so to give recommendations back to veterinarians and producers based on our results,” said Murphy.
“We get involved at the beginning, the middle, and the end,” explained Murphy. “At the beginning, a lot of time when people have an unexpected animal illness or losses, they don’t necessarily know whether it’s a toxicology problem or maybe an infectious disease problem. They just know they’re having a problem, and they need some help.”
Future plans
“The system is being expanded to include a fourth lab at Penn State’s Beaver Campus, funded in Governor Josh Shapiro’s 2024–25 budget with broad, bipartisan support,” said Hamberg. “The popular support of the lab system’s expansion demonstrates the recognition among industry partners, the General Assembly, and the Shapiro Administration of just how critical PADLS is to the Commonwealth’s economic vitality, the competitive position and stability of farms and other ag businesses, the security of our food supply, and our public health.”
Smith added that PADLS is a further demonstration of Penn’s commitment to Pennsylvania. “It’s in keeping with Penn’s strategic framework to be anchored, engaged, and interwoven in the Commonwealth in which we reside,” he said. “It is helping to protect the safety of people, it is helping to protect the safety and health of animals, it is helping to preserve the vibrancy and vitality of a very important economic industry for the state.”
This story was originally published on June 24, 2025, in Penn Today
Testing for the presence of Salmonella. (Photo: Eric Sucar/Penn Today)
BOARD OF ADVISORS WELCOMES


Michael B. Fox, W’73
Fox, a certified public accountant, is a graduate of the University of Pennsylvania’s Wharton School and the Georgetown University Law Center. Recently retired, he worked for Wang Laboratories and, most recently, for Fidelity Investments. At Fidelity, he held several senior positions in operations and financial management. Fox serves as a member of the Worcester Art Museum Board of Trustees and the Massachusetts Historical Society Advisory Council.
Fox and his wife, Mary, live in Concord, Massachusetts, with Aussie, their Australian Labradoodle. He first became acquainted with Penn Vet while working alongside some of its veterinary students in a job he held while he was a Wharton student. Passionate about dogs, Fox holds in high esteem the compassionate care and shelter medicine programs offered at Penn Vet.
Fox’s son, Michael C. Fox, W’02, and daughter-in-law, Nicole Davison Fox, W’01, also attended the Wharton School. Fox has another son, Edward W. Fox.
“Their perspectives and shared enthusiasm for Penn Vet will be invaluable as we advance our priorities and extend our impact in veterinary medicine.”
ANDREW HOFFMAN, DVM, DSC, DACVIM Gilbert S. Kahn Dean of Veterinary Medicine

Mark Korman
Korman is president of the commercial division of Korman Communities, where he oversees its retail and office holdings, in addition to all multifamily development and construction.
Korman has a long history of service, especially to youth and youth sports. He recently joined the Board of Legacy Youth Tennis and Education after transitioning off the board of Philadelphia Youth Basketball, where he still serves on the property committee. Korman is a member of the Villanova Executive Parents Committee and a former trustee of the Community Partnership School, Lower Gwynedd Little League, and the Ambler Theater. For more than a decade, he coached youth sports at all levels and counts it as one of his most fulfilling experiences.
In addition to those roles, Korman served on Thomas Jefferson University Hospital’s Real Estate Committee and various committees for the Whitpain Recreation Association, Project HOME, Germantown Academy, and Duke University.
Korman is an alumnus of Germantown Academy and Duke University (1990). A resident of Fort Washington, Pennsylvania, he is married to Kelly, and they have two children, Cameron and Quin. Korman and his wife are proud dog owners, including currently two Bracco Italianos and an SPCA rescue hound/mastiff mix. They are longtime clients of Penn Vet’s Ryan Veterinary Hospital.
Korman’s father, Steven H. Korman, founding partner of The Korman Company and former CEO of Korman Communities, is married to Linda Richardson, who is also a member of the Penn Vet Board of Advisors.
Members of Penn Vet’s Board of Advisors celebrated the groundbreaking of the Gail P. Riepe Center for Advanced Veterinary Education on April 30th at New Bolton Center, made possible through the extraordinary generosity of Board member Gail Riepe, CW’68, and her husband Jim Riepe, W’65, WG’67, HON’10, past chair of Penn’s Board of Trustees and Penn Medicine’s Board. The event highlighted the Board’s deep commitment to advancing the School’s mission, and the spirit of partnership and philanthropy that drives Penn Vet forward. Read the full story on page 6.
1. Board member Martin Winter, G’76, W’76, (vice-chair), Penn President J. Larry Jameson, Jim and Gail Riepe, Dean Andrew Hoffman, and Board member Mark Spitzer, W’71, (chair).
2. Drs. Dean Richardson and Barb Dallap Schaer, V’94, with Gail Riepe.
3. Board member Keith Morgan, C’83, and President Jameson.
4. Board members Mark Spitzer and Tamara Totah Picache, W’94.
5. Dean Hoffman and Jim Riepe.
6. President Jameson and past Board member Roy Jackson, C’61.

IN MEMORIAM





Henry “Hank” Slack McNeil, Jr.
Former Board of Advisors member Henry “Hank” Slack McNeil, Jr., passed away on July 28, 2025. McNeil served on Penn Vet’s Board from 1975 to 2004. In 1991, he endowed the Henry S. McNeil, Jr. Dean’s Scholarship, which has provided fellowships to more than 30 veterinary students since 1995. McNeil bred Labrador retrievers and was a longtime Ryan Hospital client.
On May 20, 134 members of the Class of 2025 walked across the stage at Zellerbach Theatre to receive their Veterinariae Medicinae Doctoris. Dr. Jasmin Paris, veterinary scientist and long-distance fell runner, delivered the commencement address. Class president Nina Dellarte addressed her classmates and was presented with the V’25 class flag by David Chico, V’93. Samantha Ackerley, V’25, administered the Veterinarian’s Oath.

Class of 2025
Ashley Madison Adams
Samantha Akerley
Maxwell John Babinec
Ethan Patrick Bailey
Echo Ball
Olivia Lynn Barner
Lindsay Jane Barson
Jillian Bastidas
Hannah Kaitlin Baukert
Lily Margaret Bello ♦
Estefania Dawn Benavides ●
Jordyn Emily Blew
Ermelinda Mecos Brosseau
Brianna Therese Brown ♦
Elizabeth Marie Bruzinski
Dana May Bubka
Lauren Cabrera
Austin Gerard Castellano ♦
Jesse Cecero
Gabriella Susan Cesta ♦
Bridget Cincotta
Colleen Lynn Clark
Megan Clark ★
Kaelea Catherine Composto ♦
Suna Li Cranfill ★
Atia Senia Curtiss
Sierra Daisey
Emily Irene Davidow ♦
Lisa Deinlein
Nina Noelle Dellarte
Brianna DellaVecchia ♦
George M. De Mers
Fiona Deng
Monique Rose Desrochers ♦
Katherine Connors DeWolf
Samantha Angelina Diaz ♦
Sarah DiRusso
Giovanna S DiStefano ♦
Jessica Forbes DiStefano
Clare Myrlin Dominguez
Lindsay Dwyer
Anna Lynn Eringis ♦
Katielynn Evans
Kayla Marie Even
Talia Esther Feingold
Rhiannon Ferriday ♦
Ashley Elizabeth Forster
Elisse Mackenzie Friedman ♦
Taylor Frownfelter ♦
Avery Elise Fry
Maria del Mar Fuentes Fuentes
Kayla Gantz
Delaney Ashton Garcia
Merik Elizabeth Ketrick Gillespie
Kimberly Fanya Eisler Glaser
Talia Lane Goldstein
Emily Gordon
Elizabeth Gregorio
Mary Kathryn Grubbs
Anna Hakey
Isabella Rain Halter
Rachel M. Harrell ♦
Mairin Elizabeth Heffernan
Nicole Anne Heim ♦
Sabina Izabela Hlavaty ★
Sarah Margaret Ielusic
Anthony Kimo Johnson ♦
Tatyana Renee Johnson







Cristin Elizabeth Juda
Antonina Rose Kalkus
Vlora Karpuzi
Jo Kawabata ♦
Chloe Jayne Renee Kenney
Rachel Ashley Kirk
Rachel L Kline
Sarah Elizabeth Knox
Natalie Diane Kolczynski
Emma Christine Krall
Kathryn Nicole Larsen ♦
Natalie LaScala
Benjamin Leary
Brittany Lee
Kyung Min Lee
Zachary Ryan Lee ♦
Scarlett Loya ♦



Kathryn Maguire
Lindsey Maria Maiale
Angela Maria Mangine
Amy Jayne Mann
Katherine Carmella Marciano
Rebecca Maslanka
Lindsay Nichole Matter
Justine D. McCarthy
Tiffany Linn McCarty
Cierra Naomi McKoy
William James Moorhead III
Ruchi Rajiv Mulajker ♦
Amanda Nimmo
Allison Xiaoyi Oakes
Cat Olson
Kristina Marie Opalecky ♦
Neesha Jody Palleti ♦ ▼

Sara Caroline Parnes ♦
Julia Mary Pascarella
Amanda Patev
Nimisha B. Pattada
Megan Elizabeth Pennock
Mackenzie Reed Pickford
Corisa Yvonne Quincey
Taysia Lauren Radoslav ♦
Jessica Christie Rafalko
Juliana Reynoso
Bryce Anne Ritchey
Camryn Rosen
Emilie Rucci
Rowan Schomburg ♦
Sydney Megan Schurer
Melissa Katherine Seiberlich
BrieAnna Seibert
Jacquelyn Anna Shanley
Ariel James Shepley-McTaggart ★
Stephanie Grace Sila
Chad Daniel Smiley
Claire Lilian Jane Solomon
Jessica Michelle Sommer ♦
Makayla Lauren Stone
Rachel Tevere
Brianna Trust
Devon Paige Tucker
Ashley Nicole Vanderbeck ★
Juliana Ruth Voloshin
Loren Volpe
Tiantian Wu
Kaiwen Yang

Animal Welfare and Behavior Program Graduation
On June 13, twenty-six Master of Science degree recipients were honored at Penn’s Fisher Fine Arts Library Building during the Animal Welfare and Behavior Program’s graduation weekend. Joseph Barber, PhD, gave the keynote address, and Sunday Agbonika, DVM, CHAIS, delivered the student address.



MASTER OF SCIENCE RECIPIENTS
Sunday Unekwuojo
Gift Agbonika
Madison Elizabeth Armand
Ailena Marjatta Baum
Jason Allen Bell
Dionne Marie Benson
Tia Sharee Bevier
Jelena Dosen
Lila Dougherty
Bernadette Pauline Elemi-Schoenwald
Ashley Lauren Elzerman
Amanda Farah
Kate Hornberger
Sarah Ibach
Elodie Jacques
Jessica Marie Johnston
Alessandro P Lamacchia
Margaret Leardi
Carla Monsante Edgar
Marissa Katherine Munson
Akshaya Nataraj
Alayna Dale Parsons
Alba Pfaff
Juliana Victoria Rodriguez
Sylvia Ronquillo
Zack Royle
Sophia Zahan
PENN CLIMATE INSIGHTS
A Tool for Climate Education, Action, and Community Building
BY RITA GIORDANO
Penn Climate Insights, a new internal digital platform for sharing and acquiring trusted information about climate knowledge and related research, is now accessible to the Penn campus community.
Initiated and led by Andrew Hoffman, dean of Penn Vet, the platform was launched after a year of research and development, including surveys and focus groups from the Penn community conducted by Sam Nguyen, Penn Vet’s climate innovation coordinator.
Climate Insights was designed to help educators access and integrate rigorous climate information contributed by Penn faculty and community experts into their teaching and learning experiences. It will allow the rest of the Penn community to increase climate engagement and—its founders hope—activism.
“Education is a form of empowering climate action,” Hoffman said. “That’s really what it says on our website: Climate action through education.”
Anyone with an active PennKey can access the site to explore the Insights Library of articles, recorded lectures, and slides.
Here, Dean Hoffman and early website contributors Katie Unger Baillie, director of Penn’s
Environmental Innovations Initiative (EII), and Sarah Kagan, professor of gerontological nursing, talk about their hopes.
GIVE EDUCATORS THE TOOLS TO ENABLE CHANGE
Even before he thought about building a website, Dean Hoffman believed more education was key to climate agency and action. “My interest and the interest of our community in building education about climate and sustainability was not really backed by the availability of trusted knowledge, educational platforms, or toolkits for educators,” said Hoffman.
“We hope that Penn Climate Insights will serve as the premier information-sharing and education platform for climate and sustainability for the Penn community,” he said.
Because of its open accessibility, Climate Insights can “serve as a firewall that insulates us from mis- and dis-information on critical topics,” Hoffman noted.
TEACHING CLIMATE ACROSS THE DISCIPLINES
Baillie’s role is to foster collaboration in education, research, and programs across disciplines on environmental issues. The new website is a useful tool, she said.
“It is absolutely in alignment and greatly supportive of the EII mission, which is to enlist interdisciplinary expertise from all around the University of Pennsylvania in contributing to solutions to the climate crisis and other environmental challenges,” Baillie said.
NETWORK-BUILDING TO FIGHT A HEALTH AND CLIMATE CRISIS
Sarah Kagan, professor of gerontological nursing, said Penn Climate Insights, with its bank of health and climate information, can be a network builder. She hopes many people seize that opportunity.
“That’s because this crisis is a proverbial all-hands-on-deck situation,” Kagan said. “It needs everyone’s contributions as we come together in a true sense of community for the sake of our planet and all who live on her.”
Faculty/Staff News
Gustavo Aguirre, VMD, PhD, PhD(hc), presented “Gene Therapy for BEST Disease: Translational Path from the Cage to the Clinic” at the 29th Annual Ophthalmology Symposium at the University of Colorado School of Medicine in September.
Michael L. Atchison, PhD, gave the plenary lecture at the Second International Symposium “Prognostic and Therapeutic Implications of RKIP and YY1 in Cancer, Autoimmune and Inflammatory Diseases,” held in Krakow, Poland, in April. He also received a certificate commemorating his contribution to the scientific community and the field of molecular and translational medicine.
Matthew Atherton, BVSc, PhD, presented “Developing CAR T therapy for canine lymphoma: from the clinic to the lab and back” at the VROC Symposium at UT Southwestern Medical Center in June 2025. He also presented “Fine-tuning CAR T therapy for canine hematologic malignancies” at the AKC Canine Health Foundation National Parent Club Canine Health Conference for the Foundation’s 30th Anniversary in August.
William A. Beltran, DVM, PhD, presented three lectures at the 17th VPAT Regional Veterinary Congress—7th Asian Meeting of Animal Medicine Specialties in Bangkok, Thailand, in June.
Michelle Capps, CVT, VTS (Surgery), presented an entire track of lectures for veterinary technicians at the NJVMA Veterinary Education Conference in Atlantic City, New Jersey, in May 2025. Topics included infection prevention and control in the OR, aseptic technique, surgical instrument care, sterilization, fundamentals of soft tissue surgery, and an overview of gastrointestinal surgical procedures.
Sarah F. Colmer, VMD, DACVIM (LIAM), was the international keynote speaker for the Australian and New Zealand College of Veterinary Scientists Equine Chapter Vet Science Week in July in Queensland, Australia.
Julie Engiles, VMD, was co-organizer and wet-lab instructor for the C.L. Davis-Thompson Foundation Equine Racehorse Necropsy Workshop at the University of University of Kentucky September 18-20. She also presented “Radiologic-pathologic correlation of repetitive stress and catastrophic musculoskeletal injuries of racehorses.”
Janny Evenhuis, DVM, DAVDC, was appointed assistant professor of dentistry and oral surgery.
Emily Fouraker joined New Bolton Center as director of operations for the hospital.
Alycia Frampton, VMD, DACVAA, was appointed assistant professor of large animal anesthesia.
Satoshi Haginoya, BVSc, joined Ryan Hospital’s Emergency & Critical Care team as staff veterinarian.
Katrin Hinrichs, DVM, PhD, was honored to be the 2025 Dr. Michelle LeBlanc Memorial Equine Lecturer at the annual meeting of the Society for Theriogenology in Sacramento, California, July 25, 2025. She presented “The Promise of IVF in Horses under the LeBlanc Designation.”
Katilyn Krebs, DVM, DABVP, joined New Bolton Center as adjunct assistant professor of honeybee medicine.
Dan Martzall, CJF, joined New Bolton Center as chief of farrier services.
The documentary Shelter Me: The Cancer Pioneers, by Steven Latham Productions, that showcases the work of Nicola Mason, BVetMed, PhD, FRCVS, Dr. Tim Fan (Illinois), Dr. David Vail (Wisconsin), and Drs. Steven Dow and Dan Regan (Colorado) and their efforts in comparative oncology, has been nominated for two Daytime Emmy Awards. Drs. Mason and Fan will join
Steven Latham on October 17 in Pasadena, California, for announcement of the awards.
Rose Nolen-Walston DVM, DACVIM, DACVP, has successfully passed the Phase II certifying examination in Veterinary Clinical Pathology, fulfilled all requirements, and is now double-boarded as a diplomate of the American College of Veterinary Pathologists.
Cynthia Otto, DVM, PhD, was awarded the 2025 AVMA Career Achievement in Canine Research Award, honoring her long-term contribution to the field of canine research. She also received a Lifetime Achievement Award at the first annual Joint Symposium for Working K9s in Atlanta. Otto also received the 2025 Jack Mara Scientific Achievement Award from the American College of Veterinary Emergency Critical Care at the International Veterinary Emergency & Critical Care Symposium.
Blythe Philips, VMD, DACLAM, received the American Protective Products Veterinarian of the Year Award through the Delaware Valley Branch of the American Association for Laboratory Animal Science.
Meghan Ramos, VMD, MSTR, DACVSMR, was promoted to assistant professor of clinical sports medicine and rehabilitation. She also received board certification from the American College of Veterinary Sports Medicine and Rehabilitation.
Laurel Redding, VMD, PhD, DACVMP, and Dr. Kaitlin Krebs received a grant from the University of Pennsylvania’s Kleinman Center
for Energy Policy Carl H. Goldsmith Sustainable Agriculture Fund to investigate the plant species their honeybees are foraging at New Bolton Center.
Mary A. Robinson, VMD, PhD, was promoted to associate professor of veterinary pharmacology.
Nicolina Sciaretta joined New Bolton Center as clinical manager for the hospital.
Aliza Simeone, VMD, DACVMP, became a diplomate of the American College of Veterinary Preventative Medicine.
Bernadette Smith, DVM, was appointed assistant professor of clinical equine field service.
J. Oriol Sunyer, PhD, received an Outstanding Investigator Award (R35) from the National Institutes of Health.
Regina V. Wagner, JD, MSN, MHQS, RN, infection prevention manager at Ryan Hospital, presented a poster, “Spotlight on Innovation: Behavioral Nudges in Veterinary Infection Prevention,” at the Penn Medicine 2025 Nudges in Health Care Symposium. Her poster highlighted a quality improvement initiative at Ryan Hospital aimed at enhancing hand hygiene compliance and infection prevention procedures in a veterinary academic teaching hospital setting.
Jenna Ward, DVM, DACT, lecturer in reproduction and behavior, became a diplomate of the American College of Theriogenologists.

Kenya
A Model in Sustainable Wildlife Conservation
Dean Andrew Hoffman, DVM, DVSc, DACVIM, and Julie Ellis, PhD, were the faculty hosts for a joint Penn Alumni Travel/Penn Vet trip to Kenya over the summer.
The program offers a unique experience by merging safari adventure and an exploration of Kenyaʼs commitment to conservation. Participants met with local communities and conservation experts who are working hand-inhand to ensure the survival of Africa’s endangered species.
Drs. Hoffman and Ellis gave a number of lectures centered on interconnected ecosystems, wildlife health, climate change, biodiversity, and the One Health concept, which prompted great discussion.
Tour members visited the capital city of Nairobi, Amboseli National Park, Loisaba Conservancy, and Masai Mara National Reserve, which provided for abundant game viewing.
Penn Vet alumni Susan Jacobson, V’77; Charlotte Keenan, V’77; and Juan Ferrer Perez, C’78, V’82, also attended the trip.
(Photo by Emilie LaRosa)
House Officers
This summer Penn Vet welcomed the newest cohort of house officers to New Bolton Center and Ryan Hospital. These interns, residents, and fellows are entering the next phase of their professional veterinary careers, gaining additional training throughout many of our specialty services. Penn Vet has one of the largest house officer programs in the country. Our residencies in Medicine, Surgery, and Emergency and Critical Care are the School’s largest programs, reflecting the high demand for these specialists in veterinary medicine.



It’s Official
Penn Vet’s Class of 2027 has moved up from classrooms to clinics.

With friends and family cheering them on, nearly 130 third year students gathered at the University of Pennsylvania’s Annenberg Center on September 6 for one of the veterinary school’s most celebrated transition ceremonies—White Coat Day.
One by one, they walked across the Zellerbach Theatre stage to receive the white coat of a clinician, signifying their advance from book learners to healers.
“Today marks a significant milestone: the halfway point in a journey that continues to push us, teach us and change us,” said Brooke Aguilar, V’27 class president.
Aguilar encouraged her Penn Vet classmates to find strength in the connections made in their first two years.
“I urge you to remember that we will need each other throughout our careers—and that we’ve already made it this far together. Clinics will be a different ball game, but they will prepare us for the rest of our lives,” Aguilar said.
The class paused to honor Natalie Kim, their V’27 classmate who died from complications from a
malignant brain tumor in October 2023.
Carla Chieffo, V’86, recipient of the 2025 Penn Vet Alumni Award of Merit, whose many accomplishments include anti-hunger work in Africa, urged the students to think expansively about the future.
“Our profession has no limits on what you can do,” said Chieffo.
Dean Andrew Hoffman told the students a promising future awaits them.
“This could not be a better time to enter the clinics and train to be veterinarians,” Hoffman said. “There’s lots of jobs, lots of opportunities.”
Elizabeth Arbittier, V’01, associate professor in equine field service and associate director of academic and community affairs at the New
Bolton Center, advised trust in their instructors.
“We are deeply and personally invested in turning each and every one of you into an excellent veterinarian,” she said.
David Holt, professor of surgery, offered “a bit of professional and personal advice” as they embarked on their next chapter.
“In the clinics, if you have a question about how to proceed with a case,” said Holt, “ask yourself a very simple question: ‘What would I do if it was my dog, or cat, or horse?’”
As for life: “Be the person your dog thinks you are.”
Daelyn Stabler told her fellow students from now on, they’ll always have another white coat to turn to.
“Throughout the next two years, we have each other to lean on, to answer questions, and to help us study,” said Stabler. “Once we graduate, we have the names, contacts, and shared memories of 130 other doctors we can call to bounce ideas off of or to talk to when we’ve had rough day. The people sitting next to you will understand, I promise.”
By Ashley Hinton

STUDENT TRAVELS
NIH-Boehringer Ingelheim Summer Research Program at Penn Vet exposes firstand second-year veterinary students to each phase of biomedical research. Trading beachballs for beakers, the students participating in this year’s program dove into the lab to push science further. The experience culminated with each student presenting their findings at the National Veterinary Scholars Symposium.
Eric BAI, V’28
Puré Laboratory, Penn Vet
My research investigated the interaction between FAP-CAR T cells, artificially engineered T cells that target cells that form scar tissues (fibroblasts), and specialized white blood cells (macrophages), in idiopathic pulmonary fibrosis. We revealed that these T cells can alter macrophage characteristics, enhance inflammatory signals, and promote the removal of old collagen in fibrotic lung tissue models. I learned that research can be stressful at times, but it was incredibly rewarding when results came together, especially when I could connect them to broader scientific ideas.

Ava
EHRLICH, V’28
Chen-Plotkin Laboratory, Penn Medicine
Inspired by my interest in neurology and my grandfather’s experience with Parkinson’s, this summer I studied neurodegenerative disease. I investigated how gut inflammation influences the spread of alpha-synuclein pathology along the gut–brain axis. My work involved techniques like ELISA and immunohistochemistry to measure and visualize alpha-synuclein aggregation in the gut and brain.

Margaret
PIECZ, V’27
Ortved Orthopedic Regenerative Medicine Laboratory, Penn Vet New Bolton Center
My work tested the capabilities of cutting-edge regenerative medicine treatments for equine osteoarthritis. I spent the summer looking at extracellular vesicles, signaling packets released by stem cells known for anti-inflammatory properties. We exposed the stem cells to a cytokine called IFN-g to see if the therapeutic potential of the extracellular vesicles increased. I grew up riding horses and saw firsthand how osteoarthritis can impact a horse’s quality of life. Knowing that this work could help lay the foundation for developing disease-modifying treatments has made this summer incredibly inspiring.

Emily HUGHES, V’28
Hill Laboratory, Children’s Hospital of Philadelphia
Over the summer, I characterized a novel microRNA (miRNA) involved in inter-organ communication. Our findings suggest that this miRNA may be disrupted under metabolic stress, potentially contributing to the pathogenesis of obesity, and offering a promising therapeutic target. Having really enjoyed my research experiences in undergrad, I was excited to keep exploring that side of science in veterinary school.

Jacquelin SPRING, V’28
ASMG Laboratory, Penn Vet New Bolton Center
I studied the effects of probiotics on the calf microbiome by observing if specific microbes impacted digestion. The long-term goal would be to use these probiotics to improve calf health. I developed a passion for food animal health and production medicine during my undergraduate career. I am happy to aid research at Penn Vet that can benefit the health and welfare of those animals.
SCHOLARSHIP RECEPTION
On April 26, the School hosted a scholarship reception at Penn’s Morris Arboretum & Gardens for current veterinary students who have received scholarships and the charitable donors who make it possible. Pictured below at top right are speakers Dr. Amy Durham, Dana Bubka, V’25, Gary Benjamin Lowitt, and Dean Andrew Hoffman












WELCOME
Laura Brown
Director of Alumni Relations
BY RITA GIORDANO
Ask Laura Brown, Penn Vet’s new Director of Alumni Relations, about her role at six months, and she will talk to you about people.
“That’s where it has to start,” said Brown, whose alumni relations career built connections and engagement at a diverse cross-section of learning institutions.
But Brown also sees her job as partnering with alumni to tell the rich story of Penn Vet, and that is a talent honed in her first love, theater. Active in the performing arts as a Villanova undergraduate, she stayed to earn a master’s degree in theater. Those early experiences learning to connect with people, and more, found a place to flourish in her 20-year-plus career.
Brown has deep roots in our region. Growing up in Delaware County, she lives in Chester County with her husband, a high school English teacher; their daughter, an athlete and aspiring sports journalist who recently began her freshman year at West Virginia University; and their son, a musician and high school junior. Brown is also a proud annual participant in Philadelphia’s Broad Street Run.
Brown and her team are now looking at all the ways they can engage the School’s alumni and share their stories.
RG: You just came to your post in May. How have your first six months been?
LB: It’s great that I’ve come on at this time, as our office has been in transition. A lot of new staff have come on, and we’re in the process of setting priorities. We also have a new Alumni Board president, Lindsay Shreiber. We’ve been talking about how the board can help
with initiatives that have maximum impact for the School.
RG: At your last post at Williamson College of the Trades, you increased fundraising and alumni engagement. Both are significant parts of your role here.
LB: Fundraising is so important, particularly to private institutions, but you can’t fundraise in a vacuum.
Alumni are critical to fundraising success, both as donors and as advocates to promote the institution, articulate its mission, and get others to support it.
RG: Are there strategies you would like to expand on?
LB: One of the best ways of encouraging alumni support is to provide opportunities for them to connect directly with the institution. That’s where it has to start. It might be serving on the Alumni Board, becoming a mentor within our Opportunity Scholarship Program, or helping us with outreach to their fellow classmates.
We just recruited a handful of alumni to teach some freshman labs over at Ryan Hospital. The planning began before I got here, and I support it. I’ve found when alumni are directly connected to students, they feel more invested in the institution, and they want to support it. But it all starts with engagement.
RG: We bring our various talents into the different paths we take. How have your early experiences in theater helped you in alumni relations?
LB: Theater at its heart is all about storytelling and connecting with individuals. And that is the same in alumni relations. My job is to tell the story of this institution and connect with our alumni, to make them feel part of the larger Penn Vet community.
RG: How did you move from theater to a career in education and alumni relations?
LB: I did mainly research, stage management, and production. Another skill I learned was people management. I had great lessons in learning how to understand what story people were trying to tell you.
When I started my career in the arts, I worked downtown at the Arden Theater in stage management and then got a job at the People’s Light Theater Company in Malvern. It was there that I was introduced to development and got involved in fundraising. That launched my career in development and community engagement.
RG: All the schools youʼve worked for are quite different. Can you talk about how Penn Vet fits in?
LB: I’m always attracted to organizations with a unique mission. When I was at Rosemont College, it was all women. The Delaware Valley Friends School was for students with learning challenges and learning differences. And Williamson is a trade school serving an all-male student body, with significant financial need.
Penn Vet also has a unique mission—more than people might realize. Ask a typical person what they associate with veterinary medicine, and they’ll probably name the vet they go to see for their dog or cat. But I’ve learned veterinary
medicine is so much broader. It’s an area many people don’t know enough about and that we certainly should be amplifying and highlighting.
RG: Having pets isn’t a prerequisite for working at Penn Vet, but there are a lot of animal lovers here. Do you have any pets?
LB: We have two cats that run our household: Mathilda, who is three years old, and Benjamin, who is two. We believe Mathilda is part Russian Blue. Benjamin is just a good old black cat. Both were adopted at the Providence Animal Center in Media, whose medical director is a VMD.
Having animals has taught us a lot as a family about patience and sharing space. It’s taught us a lot about empathy, too. Even my husband, who was kind of resistant to the cats, may be their biggest fan now.
RG: Do you have any parting thoughts you would like to leave your readers?
LB: I’m truly honored to be in this role. This is a large and complex institution, but I feel Penn Vet is such a supportive community of doctors, staff, and faculty, all of whom really believe in the work we’re doing. My goals are to continue building our alumni community, to get to know as many alumni as I can, and to make sure they know that they always have a home here.
We hope they will continue to stay involved and connected because we need them.

FROM THE ALUMNI BOARD
Lindsay Shreiber, V’91
Board President

I am honored to serve as President of the Penn Vet Alumni Board for the 2026 and 2027 academic years.
Our board comprises more than 30 members representing a range of graduating years and veterinary specialties. Our main focus is to support and promote Penn Vet’s mission by engaging Penn Vet alumni, students, faculty, and the greater community.
As a private small animal practitioner, I recognize not only my role in caring for some of the most important beings in my clients’ lives, but also my responsibility to the entire spectrum of animal, human, and environmental health. Over the past several years, we have seen veterinarians emerge as key global health leaders. The One Health approach, which acknowledges the interconnectedness of human, animal, and environmental health, highlights the importance of veterinary medicine in balancing and sustaining the health of all. As Penn Vet alumni, we are well-positioned to make a meaningful impact.
I invite you to join me in making this impact at Penn Vet through any number of ways: Attend alumni events—your participation strengthens our network and promotes the School; volunteer to serve on an alumni board committee, mentor students, facilitate continuing education seminars, or host alumni gatherings; give to support scholarship, research, and the transformative and innovative work happening every day at Penn Vet; and stay connected and informed—follow Penn Vet on social media and update your information with the alumni office to receive the latest communications and news from the School.
I look forward to serving as your alumni president, and I encourage you to share your ideas for programs, initiatives, and collaborations.
Please reach out to the alumni office with your feedback, ideas, and any questions by email at vetalumni@vet.upenn.edu or call the alumni office at 215.898.1481. I look forward to seeing you on campus soon.
Alumni Awards
2025 DISTINGUISHED ALUMNI ACHIEVEMENT AWARD
David Chico, V’93
Dr. Chico earned his BS in toxicology from the University of the Sciences in Philadelphia (now Saint Joseph’s University) and his MPH in epidemiology from the University of Albany. He is board-certified by the American College of Veterinary Preventive Medicine and serves as assistant state veterinarian in the New York State Department of Agriculture and Markets.
Chico’s three-decade career as a veterinarian is marked by a profound and sustained commitment to advancing animal health and welfare on multiple fronts. Chico served as president of the National Alliance of State Animal and Agricultural Emergency Programs, a national network of state animal and agricultural emergency programs that advocates and prepares for animal and agricultural emergencies. In 2008, Chico founded a free pet wellness clinic in partnership with Albany Damien Center’s Pets Are Wonderful Support (PAWS) program to provide veterinary care to low-income, HIV/AIDS pet owners. He has participated in international animal aid and humanitarian efforts during the 2013 aftermath of Typhoon Haiyan in the Philippines. In 2016, volunteering with Animals Lebanon, Chico rendered care in Beirut during the Syrian refugee crisis; and in 2022, he assisted Ukrainians and their pets fleeing war at the Medyka Border Crossing in Poland. Chico was awarded the 2018 American Humane Hero Veterinarian Award, defining a career not only of technical excellence, but also of enduring social responsibility and global impact.
2025 ALUMNI AWARD OF MERIT Carla Chieffo, V’86, GR’98
Dr. Chieffo earned her BS in animal production sciences and her MS in veterinary science from the Pennsylvania State University. After receiving her VMD degree, Chieffo entered private practice before returning to Penn Vet to complete her residency in medical genetics, pediatrics, and reproduction. Upon completion of her residency, she went on to earn her PhD in pathobiology from the University of Pennsylvania. Chieffo spent 20 years in the pharmaceutical and biotechnology sectors with roles at Pfizer, GlaxoSmithKline, Endo Pharmaceuticals, and Janssen Pharmaceutics, leading medical and clinical sciences in early-stage drug development. She left industry to work in the nonprofit sector as a community-focused veterinarian and is now President of the Board of Directors of The Spayed Club Veterinary Clinic, a non-profit that provides affordable veterinary care to companion animals. Chieffo is a long-time advocate of veterinary education, serving in a variety of School volunteer leadership roles for almost four decades. She is the founding member of the Gambia Goat Dairy, now Fair Farms Gambia, a demonstration and research farm in West Africa that promotes circular food systems, environmental stewardship, and social responsibility. Chieffo is the author of several published scientific articles and has presented at scientific meetings throughout her career. She has also been active within her community as a volunteer, taking on a variety of leadership roles.


FROM LEFT
Alumni Director Laura Brown, Dr. David Chico, Dr. Carla Chieffo, and Dean Andrew Hoffman
ALUMNI & REUNION WEEKEND
MAY 17, 2025
Penn Vet welcomed more than 170 alumni, family, and friends to the Philadelphia campus. The celebration kicked off with a 50th reunion brunch followed by tours of Ryan Hospital, Hill, and Old Vet Quad. Alumni awards were presented to Drs. David Chico and Carla Chieffo during the picnic.













PASSING ON A PENN VET LEGACY
A Love of Animals and the Land
By Rita Giordano

The Penn Vet of Dean Snyder, V’54, was a very different place than today. So was the world.
Back then, there were only two women in Snyder’s class. And Snyder, the son of Central Pennsylvania farmers of modest means, would become one of the first graduates of the newly acquired New Bolton Center. Purchased in 1952, students arrived in 1953, and it was formally dedicated in 1954.
Not the developed campus of today, Snyder recalled the dairy and some stables, cattle, horses, and pigs. But the education Snyder received there was more than enough to kick-start a long, long career that led this country boy with a restless spirit and a curious mind across the states and beyond. He helped develop agricultural innovations still in use today.
“I had some good breaks during my time at Penn,” noted Snyder wryly, now 98.
He also inspired a family legacy—a devotion to animals and the land— that’s carried over generations.
“I was so inspired by his career path,” said Jane Annand, V’18, 36, one of Snyder’s grandchildren who
is now a small animal veterinarian in Maryland. “I always wanted to be a vet, and I think it was because of him.”
When Annand graduated from Penn Vet, Snyder presented her with her diploma.
“I was very proud,” Snyder said.
Humble beginnings on a family farm, and meeting a country vet
It all started many years ago on Snyder’s family farm. As a boy, he helped his mother with the farm chores.
“We had a grocery route once a week, and we’d dress a lot of chickens for that,” Snyder said. “I did some of the milking.” He also did the weeding, but without the aid of modern equipment. “I was the scythe guy,” he said, chuckling. “I just loved agriculture.”
Then one day, when the family mule sustained a dislocation injury, Snyder, still a teenager, made an important acquaintance: a veterinarian.
The clinician, part of a local family of veterinarians, put the mule in a device that allowed him to heal. Snyder still recalls how impressed he was. It sparked his imagination.
“It was something I could aim for,” Snyder said.
As much as he loved farming, he didn’t see a future in it for him. The family farm was very small. As it was, he hitchhiked ten miles each way to high school. Money was scarce.
“I grew up during those Depression years,” Snyder said. “We’d get one pair of shoes a year, and as I outgrew them, I cut the toes out so I could wear the shoes. In summertime, I threw them away and went barefoot.
“In my senior year, an Army recruiter came in and gave us a pitch. I went up to him after his presentation, and I asked him if I joined the Army, could I get shoes every time I needed them? He said, ‘Certainly.’ So, I signed up.”
Snyder was shipped out to Europe. But the Army paid for education, too. Snyder got to earn
his undergraduate degree, in the process meeting his wife, the stylish and whip-smart Agnes Marion Millard, a fellow student at Lebanon Valley College. He would be called up again to serve during the Korean War. Through the G.I. Bill, he fulfilled his long-held dream: he entered the University of Pennsylvania’s School of Veterinary Medicine to become a veterinarian.
A Penn Vet student and the makings of an inspiring career
It was a different time in many ways. Women now make up the majority of Penn Vet students, and veterinary students in general. That was not the case in the 1950s. And in society at large, the second wave of the feminist movement was still years away.
During a recent interview, family members talked about how Marion, now 97, herself a force to be reckoned with who ran the household and raised the children while Snyder traveled for his career, helped her husband get through all those difficult anatomy class memorizations.
Marion’s family had two large beef cattle operations, Millarden Farms in Annville and another farm in Georgia. After graduation, Snyder became the veterinarian for both, with access to a private plane to travel between the two. That continued for more than a decade, until the family decided to exit the business.
But soon a new door opened. Through colleagues from the Penn State Stockmen’s Club, Snyder went to work for Eli Lilly. There he embarked on a long career in applied science, helping to develop
the use of cattle breeding practices that are widespread today, such as estrus synchronization to allow more efficient use of artificial insemination, as well as vaccinations in poultry. Annand, his granddaughter, said that while she was an undergraduate at Colorado State University, she met ranchers who had worked with her grandfather while he was developing his cattle breeding protocol many years before.
“It was a really cool moment for me,” Annand said.
Annand grew up listening to her grandfather’s stories about life on the farm.
“A lot of it was just so romantic,” she said. Like hearing about memories of Christmas mornings checking on the cows.
And while Snyder came from a time when men and women often had separate pursuits—females in the home, males out in the world—he didn’t treat his girl offspring that way. Growing up, Annand recalled that she and a same-age female cousin were often their grandfather’s companions of choice on many adventures.
He was an avid bird watcher and beekeeper, and the girls shared in those forays. Annand’s curiosity led her to amateur autopsies on deceased woodland critters she found, just as her grandfather had done as a boy, and he certainly did not discourage her.
“And he always had stories to tell,” she said. “He always just had the best stories.”
He always had dogs, too, she recalled. Mostly English springer spaniels. He trained them to be good bird dogs, and her grandmother taught them to behave in the house.
“I inherited his love of animals,” Annand said.
And while she’s the only grandchild to become a veterinarian, she said several of her siblings and cousins found careers in the sciences, and all inherited their grandfather’s love of nature and benefited from their grandmother’s sense of style and grace.
At the retirement community where the couple now reside, Snyder still enjoys the feel of the earth; he gardens regularly and takes daily walks—up to three miles a day. He walks with the aid of a cane he made himself. He still does woodworking. Annand now has her own children. Although they are only three and 18 months, already she is passing down the lessons learned during her childhood, many from the times spent with her grandfather. They know that puddles are to be splashed in, and that nature walks are times for exploring. She takes them to look for birds like those in their great-grandfather’s Audubon books. And they’re frequent visitors to the Chesapeake Bay that surrounds where they live. She says she wants their childhood to be like the one her grandfather helped give her.
“Probably the most inspiring thing about my grandfather is just the fact that he’s always had this sense of wonder,” Annand said. “He always found something to be interested in. That’s the legacy that lives on today.”


Class Notes
1970s
Dean M. Cauffman, V’75, celebrated 50 years of service at an anniversary event on July 19, surrounded by family, friends, clients, and Penn Vet classmates, including Greg Sykes, V’75, Kenneth Sanders, V’75, Kathy Tracy, V’75, and Bernie Farrell, V’76 Cauffman was recognized by Pennsylvania Secretary of Agriculture Russell Redding, PA Representative Perry Stambaugh, and representatives from the offices of Senators John Fetterman and David McCormick. Thomas Parsons, V’86, Marie A. Moore Professor of Animal Welfare and Ethics, spoke during the program about the work of Penn Vet’s Center for Sustainable Agriculture and Food Security.
1980s
Randy D. Aronson, V’80, an integrative veterinarian, launched the podcast Paws, Reflect & Heal to educate pet owners on animal longevity and wellness. Aronson also owns Paws Veterinary Center in Tucson, Arizona, and speaks at veterinary schools and conferences across the United States.
James F. Dougherty, V’80, was elected vice-chair of the Rutgers University Board of Governors.
Gary M. Tabor, V’87, founder of the nonprofit Center for Large Landscape Conservation, will retire from his role as CEO. Having championed landscape-scale and connectivity conservation on six continents over the last 40 years, Tabor developed an entirely new sector of conservation theory and practice. He has co-authored more than 100 scientific papers and reports and has inspired countless conservationists through the presentations and speeches he has given worldwide.
1990s
Karen Froberg-Fejko, V’96, (VM’27), was elected vice president of the American Association for Laboratory Animal Science.
2000s
Jacob R. Werner, V’00, was appointed Director-United States of America by the Association for Assessment and Accreditation of Laboratory Animal Care International (AAALAC). In this role, Werner will oversee AAALAC’s education and outreach program within the U.S. as well as serving as one of the staff members representing AAALAC International and promoting AAALAC’s mission worldwide.
2010s
Heather Fowler, V’10, was appointed to the New Jersey One Health Task Force, which is overseen by the New Jersey Department of Agriculture in collaboration with the Departments of Health and Environmental Protection.
Emma Gorenberg, V’14, completed her residency in anesthesia at Penn Vet and passed her board certification examination to be named a diplomate of the American College of Veterinary Anesthesia and Analgesia.
Major Erin Hennessey, V’13, a diplomate of the American College of Veterinary Radiology and chief of radiology at the Daniel E. Holland Military Working Dog (MWD) Veterinary Hospital, assisted Major William Ciancarelli, V’19, Deputy Commander of the Veterinary Readiness Activity (VRA), Hawaii, in diagnosing a rare two-inch osteochondral fragment compressing the spinal cord, known as osteochondrosis dissecans, for a MWD at the VRA. The diagnosis and subsequent surgery lead to a full recovery for the MWD.
Nikhil Joshi, V’15, appeared on three episodes of “Jeopardy!” in early June, winning $20,199.
Class Notes
Harathi Krishnan, V’17, currently employed with NorthStar Vets, completed her certification as a Diplomate of the American College of Veterinary Ophthalmologists.
Meghan Ramos, V’18, was named assistant professor of clinical sports medicine and rehabilitation. Ramos also serves as the medical director at the Penn Vet Working Dog Center.
Amy Smagala, V’11, and her twin sister Dr. Jenni Smagala opened Twin Tails Veterinary Hospital in Garnet Valley, Pennsylvania, in June.
2020s
Captain Ross Pillischer, V’22, graduated as a Distinguished Honor Graduate from Air Assault School, Hawaii. Air Assault School is among the most demanding U.S. Army courses that rigorously trains soldiers in airmobile operations, sling load operations, and rappelling techniques. Successful completion earns graduates the coveted Air Assault Badge, signifying their expertise in airmobile operations and their ability to thrive under pressure. Pillischer is currently stationed at the Veterinary Readiness Activity, Guam.
IN REMEMBRANCE
1950s
Lea McGovern, V’55
April 10, 2025
Lexington, Virginia
John E. Quatroche, V’52
May 19, 2025
Punxsutawney, Pennsylvania
1960s
James H.U. Hughes, V’60
July 19, 2025
Wilmington, Delaware
James E. Stiteler, V’62
August 17, 2025
DuBois, Pennsylvania
1970s
Henry D. Ferris, Jr., V’74
April 18, 2025
Naples, Florida
Robert A. Rushmer, V’75
June 8, 2025
Paradise, Pennsylvania
1980s
Michael J. Herman, V’81
August 26, 2025
Greensboro, Georgia
Craig W. Holbrook, V’84
May 20, 2025
Lebanon, Maine
Email your news to the alumni office at vetalumni@vet.upenn.edu, or write to us at Alumni Relations, Penn Vet Alumni Office, 3800 Spruce Street, Suite 151E, Philadelphia, PA 19104. We may edit submissions for space.
Lawrence R. Soma, VMD, DACVA
Lawrence R. Soma, age 92, of Bolton, Connecticut, passed away peacefully September 8, 2025, from heart failure.
Born in Queens, New York, in 1933, Soma studied at the University of Connecticut from 1950 to 1953 before earning his VMD from Penn Vet in 1957. After graduating, he proudly served his country in the U.S. Army Veterinary Corps. He was commissioned as a captain, serving on active duty from 1958 to 1960, and in the Army Reserve from 1960 to 1966 during the Vietnam War era. Soma returned to Penn Vet in 1960, first as a resident, then as a fellow, and finally as instructor. He started on the faculty in 1964 as an assistant professor and went on to become professor of anesthesia and clinical pharmacology. He served as chair of the department of Clinical Studies starting in 1975. Soma was named the Marilyn M. Simpson Professor of Veterinary Medicine in 1993.
A founding member of the American College of Veterinary Anesthesia and Analgesia, Soma was internationally recognized for his contributions to veterinary anesthesia and clinical pharmacology. He served on numerous school and University committees, including multiple terms
on the Committee on Appointments and Promotions, the Committee on Academic Status of Students, and the Institutional Animal Care and Use Committee, where he also served as chair. He also served as principal investigator for the Pennsylvania Horse and Harness Racing Commissions’ research program, a position he held until his retirement in 2013.
He and his collaborators at the Pennsylvania Equine Toxicology and Research Laboratory, including Fuyu Guan, research professor of equine forensic chemistry, were the first to develop a method for confirming blood-doping agents—recombinant human erythropoietin (rhEPO) and darbepoetin-alfa (DPO)—in racehorses by testing plasma using liquid chromatography and mass spectrometry. For this work, Soma and his colleagues were honored by the U.S. Harness Writers Association. Additionally, his work to determine the difference between normal and abnormal levels of testosterone in horses led to the first ban on anabolic steroids in the country.
Just before retirement, his team began exploring the value of proteomics, transcriptomics, and metabolomics to the field of forensic pharmacology—a mission that has been carried on by Mary A. Robinson, VMD, PhD, DACVCP, with continued support and

advice from Soma in his role as professor emeritus.
“I was deeply saddened by his passing,” said Robinson. “In addition to his numerous scholarly contributions to veterinary anesthesia and forensic pharmacology, he was an incredibly kind and generous person and mentor. He helped me merge my passion for horses, veterinary medicine, and pharmacology, and quite literally changed the course of my life. I am so thankful I had the opportunity to work with him.”
Soma is survived by his wife of 70 years, Joan; sons Scott, Mark, and Craig; grandchildren Bon, Jaeke Lyn, Tyler, Paul, Alexander, and Avery; and great-grandchildren Rory and Camila.
In lieu of flowers, memorial contributions may be made to Penn Vet at https://pennvet.org/ friendsofnbc.
Rebecka S. Hess DVM,
MSCE, Dipl.
ACVIM
By Mary Beth Callan, DVM, DACVIM; Nicola J. Mason, BVetMed, PhD, DACVIM, FRCVS; and Ariel S. Mosenco, DVM, DACVIM
Rebecka S. Hess, a gifted clinician, an award-winning educator, an inspiring mentor, a prolific scholar, a natural leader, and a dear and much respected colleague and friend, passed on June 1, 2025, after a courageous seven-year battle against cancer. She was 64 years old.
Rebecka graduated from the Hebrew University of Jerusalem Koret School of Veterinary Medicine in 1993. She made Philadelphia her home for the next 30-plus years, completing a small animal rotating internship and internal medicine residency at Penn Vet and eventually joining the faculty. She achieved board certification by the American College of Veterinary Internal Medicine in 1997. She quickly rose through the ranks at Penn and was promoted to professor of medicine in 2013. While Rebecka maintained her interest and expertise in general small animal internal medicine, her area of passion and clinical research was endocrinology, particularly diabetes mellitus.
Rebecka was an outstanding teacher, receiving the first six teaching awards in 1998. Penn Vet honored her with the Alumni Excellence in Teaching Award in 2013, and the University of Pennsylvania recognized her tremendous impact on education both in the classroom and clinics with its highest honor, the Christian R. and Mary F. Lindback Award for Distinguished Teaching, in 2019. As a clinical faculty member, Rebecka had an even greater impact on the education and mentoring of countless house officers, including more than 100 internal medicine residents, who she inspired each day to achieve their clinical and research goals. She was particularly adept at engaging students and house officers in clinical research and guiding them through their research projects, from formulating a hypothesis, to drafting the proposal, collecting and analyzing data through to submitting their manuscripts for publication. Over the years, six residents mentored by Rebecka received awards at the ACVIM Forum for their research abstracts, a testament to the quality of her research and her skill in preparing residents for their presentations.
During a sabbatical year Rebecka opted to return to the classroom as a student herself, earning a Master of Science in Clinical Epidemiology degree from the Perelman School of Medicine at the University of Pennsylvania in 2017, further enhancing her own skills as a researcher and allowing her to provide invaluable support to

her colleagues and collaborators with study design and statistical analysis. Her clinical research resulted in numerous impactful publications, with the European Society of Veterinary Endocrinology recognizing her for exceptional contributions to the field of veterinary endocrinology with honorary membership in 2023.
Rebecka’s
professionalism, integrity, ability to listen, and respect for others made her a natural leader.
Rebecka’s professionalism, integrity, ability to listen, and respect for others made her a natural leader. She served as chief of the section of medicine at Penn Vet since 2008, strongly advocating for her team. The hospital administration valued her leadership and sage advice, which resulted in her serving on and chairing several department and school committees.
Despite her battle against cancer, Rebecka remained an active full-time faculty member until one month before her passing. Her remarkable strength and determination inspired everyone around her, helping others to put small challenges into perspective and truly appreciate what is important in life. Her impact on the veterinary profession and the many lives she has touched will be long-lasting and very much cherished.
The Rebecka Hess Memorial Scholarship Fund has been established in her honor and provides financial support to graduate students at Penn Vet. Donations may be made at https://pennvet.org/ hessmemorialscholarship
Larry L. Laster, PhD
Larry L. Laster, an emeritus professor of epidemiology and biostatistics in clinical studies in Penn Vet and a former associate professor in Penn Dental Medicine, died on May 16. He was 84.
Laster earned his BS in experimental psychology and mathematics from Pennsylvania State University in 1962, then came to Penn to earn his MA in biostatistics (1966) and PhD in economics, regional science, statistics, and educational psychology (1974). While at Penn, he worked as a statistician at the Kelly Foundation for Medicine and Public Health and completed a summer program in biostatistics at Yale University. In 1964, while working on his MA, Laster joined Penn’s faculty as an instructor in oral medicine at Penn Dental. He spent the next decade and a half as a member of Penn Dental’s research faculty, specializing in biometrics, before joining the tenure track in 1978 as an associate professor. He served in this role until 1997, when he moved to Penn Vet, becoming a professor of clinical sciences and advanced medicine.
Throughout his decades at Penn, Laster published peer-reviewed articles that related to both dental medicine and veterinary medicine. He retired from Penn and assumed emeritus status in 2009.
Laster is survived by his wife, Hong Yang; his children, Jeremy (Megan) Laster, Lori (Stanton Wood) Laster, Amy (Blake) Poe, and Emily Laster; his stepchild, Haohua Chen; and his grandchildren, Hattie and Piper Laster, Shiloh and Sacha Laster Wood, Torrey and Layla Poe, and Vincent Shepherd III.
Contributions in Laster’s memory may be made to St. Jude Children’s Research Hospital at www.stjude.org.
For more information and to view a full list of upcoming events, visit www.vet.upenn.edu/events
December 8
ALUMNI RECEPTION AT AAEP
Denver, CO
January
17
ALUMNI RECEPTION AT VMX
Orlando, FL
May 15-16
ALUMNI AND REUNION WEEKEND
Philadelphia & New Bolton Center Campuses
18
V’26 COMMENCEMENT
Philadelphia Campus
PENN VET
WWW.VET.UPENN.EDU
PENN VET
@PENNVETSCHOOL
@PENNVET
NEW BOLTON CENTER
PENN VET NEW BOLTON CENTER
@NEWBOLTONCENTER

Last Word
Penn President J. Larry Jameson gathers with Penn Vet students and house officers at New Bolton Center following the groundbreaking of the Gail P. Riepe Center for Advanced Veterinary Education in April.
United Way of Greater Phila. & So. NJ: #50178
Our mission at Penn Vet is to train the next generation of veterinary leaders to advance healthcare outcomes and access, ensure global health, bolster sustainable agriculture, create and support interdisciplinary career paths, and foster community and wellness in the profession.